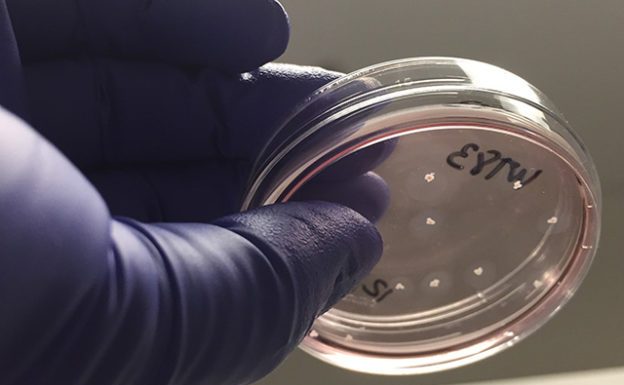

武漢爆發不明原因肺炎疫情,香港截至昨天中午共通報 8 起疑似病例,短短 1 天再增 6 例。疾管署說,若香港個案確診不明肺炎且有擴散疑慮,才會評估調整對港管制措施,將持續監測。
2018 年 11 月,中國基因編輯寶寶引起舉世譁然!這個事件的前因,要追溯到 2012 年橫空出世的基因剪刀 CRISPR,讓人類從此可精準、快速、便宜的編輯 DNA。但這把剪刀目前還有技術瓶頸,只適合治療可拿出體外的免疫細胞。《研之有物》邀請中研院生物化學研究所、專研 CRISPR 的凌嘉鴻助研究員,介紹這項正在翻轉世界的基因神器。
德國化學大廠拜耳(Bayer)經過 2 年的「愛情長跑」,才終於通過美國司法部與歐盟的反托拉斯審核,得以在 2018 年購併種子與農藥大廠孟山都(Monsanto),原本拜耳預期迎來農藥與基改種子結合的完美婚姻,沒想到購併後反而先受害,惹上孟山都知名產品除草劑年年春(Roundup)的官司大麻煩,股價一路滑落,不過現在事情有了轉機,2019 年 12 月 23 日美國環保署與司法部在年年春官司上力挺拜耳,使得拜耳股價應聲上漲慶祝。
武漢不明肺炎已排除流感、SARS、MERS 等已知病原,疾管署今天說,病毒是否具人傳人能力將成未來觀察重點,若過了病毒潛伏期、1 月 14 日後沒有新病例出現,人傳人風險將降低。
心房顫動(心律不整)患者中風風險比一般人高 5 倍,中央大學團隊研發智慧手錶,可隨時量測心電圖,用在慢性病追蹤或高危險群辨認,是潛在中風高風險者的福音。
發生在幼童身上危及生命的腹瀉症狀,可能與反聖嬰天氣現象有關。 春秋換季之時也是幼童腹瀉高峰期,在先進國家因為有良好醫療體系,腹瀉只要及時治療便無大礙,然而在低收入和中等收入國家中,腹瀉是 5 歲以下兒童第二大死因,其中 72% 幼童多於 2 歲前夭折;非洲 5 歲以下兒童腹瀉率特別高,估計每 1 名兒童每年發生 3.3 次腹瀉。
中國南開大學研究人員成功將成年小鼠的顆粒細胞(granulosa cell)重新編程為誘導性多能幹細胞(iPSC)並分化為卵母細胞,再透過正常受精成功產生健康的小鼠後代。
消費性電子展 CES 將會在 1 月 6 日揭幕,三星屆時會發表名為 NEON 的人造人(Artificial Human)計畫。三星預告 NEON 並非由智慧助理 Bixby 衍生的產品,消息一出立刻引起外界很多揣測,有消息指 NEON 其實是人工智慧平台,由位於美國的 Samsung Technology and Advanced Research Lab(STAR 實驗室)負責。
一年一度 CES 消費者電子展將於 1 月 7~10 日在美國拉斯維加斯舉行,今年參展的科技品牌出現一位稀客,就是一般不會以官方名義出席的蘋果。據《彭博通訊社》編輯 Mark Gurman 爆料,蘋果將參展並推廣 HomeKit 智慧家居系統。